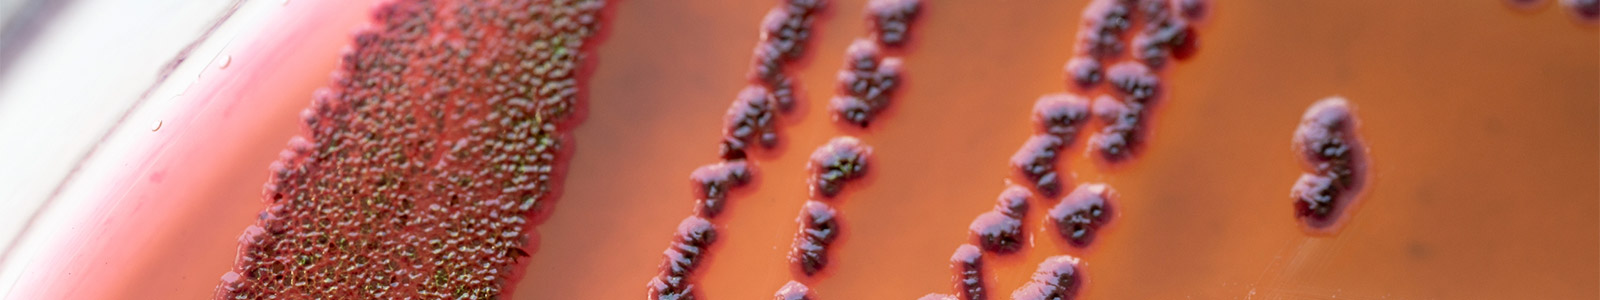
anti-microbial resistance

AMR Hub at Queen's
VISION
The AMR Hub is a platform for cross-faculty inter-disciplinary interaction bringing together diverse expertise and technologies between researchers at Queen's University Belfast, to tackle a critical global problem and find effective and sustainable solutions to tackling AMR through collaboration with the public sector and business community.
MISSION
- To deliver specialised training and research programmes which inspire the next generation of researchers in the area of AMR and One Health.
- To attract multi-sectoral and transdisciplinary funding to promote antimicrobial stewardship through epidemiology, surveillance, diagnostics and discovery science in relation to AMR.
THEMES
- Innovation for novel diagnostics and surveillance for AMR in real time
- Emerging Technologies in Disease Prevention, Diagnostics and Therapy
- Discovery and optimisation of anti-infectives for crop, veterinary and human infections
- Harnessing big data, computational technologies, and Machine Learning for AMR solutions
- Optimising AMR advances via stakeholder engagement
Would you like to join us?
Email the Hub